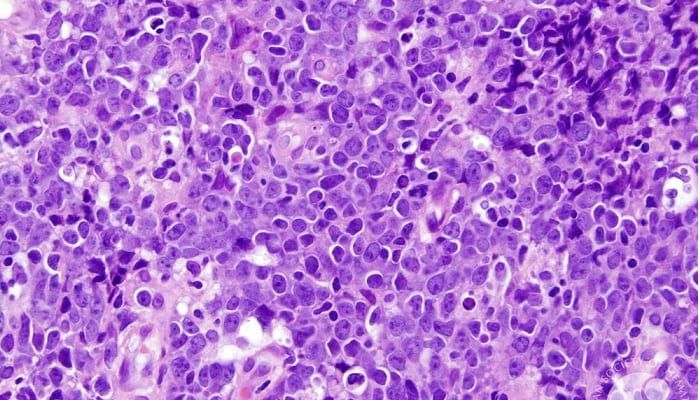
Investigators will assess LP-284 as a treatment for those with B-cell non-Hodgkin lymphoma in a phase 1 trial.

Lymphoma
Latest News
Latest Videos

CME Content
More News

Investigators report that response-adapted trials utilizing novel combination regimens appear to be safe and feasible in a population of patients with newly diagnosed diffuse large B-cell lymphoma.

Zanubrutinib plus obinutuzumab and venetoclax appears to be well tolerated in patients with TP53-mutated mantle cell lymphoma, says Anita Kumar, MD.

The addition of venetoclax to ibrutinib yields a favorable benefit/risk profile in patients with relapsed/refractory MCL, according to data from the phase 3 SYMPATICO trial.

A first-in-human phase 1a/1b trial will evaluate the dose escalation of NX-1607 in patients with persistent lymphoma, including those with diffuse large B-cell lymphoma.

Pirtobrutinib may be a clinically meaningful option for those with relapsed/refractory follicular lymphoma, although additional data are necessary, says Nirav N. Shah, MD.

Investigators report no new safety signals in patients with relapsed/refractory follicular lymphoma following treatment with tisagenlecleucel infusion.

Brentuximab vedotin plus nivolumab, doxorubicin, and dacarbazine appears to be well tolerated in patients with advanced stage classical Hodgkin lymphoma, according to data from the phase 2 SGN35-027 trial.

Single-agent treatment with odronextamab continued to demonstrate encouraging clinical activity, along with a manageable safety profile, in patients with relapsed/refractory diffuse large B-cell lymphoma.

Auto-HCT results in higher overall survival compared with CAR-T cell therapy in patients with relapsed large B-cell lymphoma while they are in complete response, according to findings from a retrospective study.

Data from the ZUMA-7 trial shows that age alone should not be a barrier of consideration of administering CAR T-cell therapy to patients with large B-cell lymphoma, says Marie José Kersten, MD.

A 70% overall response rate was observed when bridging therapy was added to axi-cel for patients with relapsed/refractory large B-cell lymphoma.

The phase ZUMA-2 trial showed safe and efficacious responses for patients with relapsed/refractory mantle cell lymphoma treated with brexucabtagene autoleucel.

Median overall survival appears to be higher in patients who were previously treated with relapsed/refractory mantle cell lymphoma and who receive brexucabtagene autoleucel compared with standard therapy.
Investigators will assess LP-284 as a treatment for those with B-cell non-Hodgkin lymphoma in a phase 1 trial.

Data from the phase 1/2 EPCORE NHL-1 trial support the FDA breakthrough therapy designation for epcoritamab-bysp in patients with previously treated relapsed/refractory follicular lymphoma.

Data from the phase 3 CHRONOS-4 study highlight that copanlisib did not reach the primary end point of progression-free survival among patients with relapsed follicular lymphoma.

Panelists close the discussion by offering insights and future perspectives on the treatment landscape for follicular lymphoma.

The 3-year PFS rate for patients with MCL was 94%, and the OS rate was 97%

Data from a phase 2 trial support lenalidomide plus rituximab as a novel treatment strategy for patients with previously untreated mantle cell lymphoma.

An expert discussion surrounding the evolving treatment landscape for relapsed or refractory follicular lymphoma in the third-line setting and beyond.

Faculty review potential adverse events (AEs) seen in patients receiving treatment with bispecific antibodies and discuss preferred strategies for AE management.

Expert oncologists offer considerations for the use of CAR-T therapy and bispecific antibodies in follicular lymphoma and discuss potential challenges that may limit the use of these agents in clinical practice.

An overview of the evolving role of CAR-T therapy in patients with relapsed or refractory follicular lymphoma.

The primary end point of overall response rate is met in the phase 2 ROSEWOOD study of patients with relapsed/refractory follicular lymphoma receiving zanubrutinib plus obinutuzumab vs obinutuzumab monotherapy.

Sobuzoxane plus etoposide and rituximab may be safe and effective in a subgroup of elderly patients with diffuse large B-cell lymphoma and low tumor burden.























































